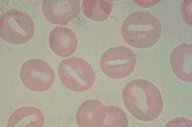

Description
Stomatocytes: This red cell abnormality is seen in this high oil
Wright's stain photomicrograph of the peripheral blood. Instead of the
normal circular area of central pallor, a slit resembling a partially
open mouth is seen-hence the term.
|
|
Click on this image
to enlarge it, then
on Back buttom
in the Netscape Menu
to shrink it back down



|